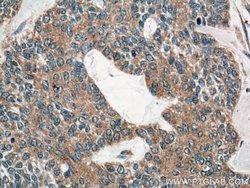
IL1 beta Mouse anti-Human, Clone: 2A1B4, Proteintech 20 &mu;L; Unconjugated:Antibodies

missing translation for 'onlineSavingsMsg'
Learn More
Learn More
Descrizione
Interleukin-1 beta (IL-1 beta) is a proinflammatory cytokine expressed by monocytes, macrophages, and dendritic cells. IL-1 beta is synthesized in response to inflammatory stimuli as a 31 kDa inactive pro-form that accumulates in the cytosol. Cleavage of pro-IL-1 beta into the active 17 kDa protein requires the activation of inflammasomes, which are multi-protein complexes that respond to pathogens, stress conditions, and other danger signals. Inflammasome activation triggers the processing of the caspase-1 precursor into its active form, which in turn cleaves pro-IL-1 beta. IL-1 beta lacks a signal sequence peptide for classical ER/Golgi pathway and is secreted alongside caspase-1 via an alternate and incompletely understood mechanism. Although IL-1 beta is most often secreted in its active form, secretion of the uncleaved protein may be detectable under some biological conditions. IL-1 beta signals through two receptors, IL-1RI and IL-1RII, both of which are shared with IL-1 alpha. IL-1 beta activity can be moderated by IL-1 Receptor Antagonist (IL-1RA), a protein produced by many cell types that blocks receptor binding through competitive inhibition. IL-1 beta play an important role in innate host defense by triggering the production of other proinflammatory cytokines in target cells and initiating acute-phase responses to infection and injury. Elevated levels of IL-1 beta have been associated with many chronic inflammatory conditions IL-1 beta neutralizing antibodies potential therapeutic value.
Specifica
Specifica
| Antigene | IL1 beta |
| Applicazioni | Western Blot, Immunohistochemistry (Paraffin) |
| Classificazione | Monoclonal |
| Clone | 2A1B4 |
| Concentrazione | 1 mg/mL |
| Coniugato | Unconjugated |
| Formulazione | PBS with 50% glycerol and 0.1% sodium azide; pH 7.3 |
| Gene | IL1B |
| N. accesso geni | P01584 |
| Alias gene | Catabolin, IL 1, IL 1 beta, IL1 BETA, IL1B, IL1beta, IL1F2, Interleukin 1 beta, interleukin 1, beta |
| Vedi altri risultati |
Titolo del prodotto
Facendo clic su Invia, l'utente riconosce che potrebbe essere contattato da Fisher Scientific in merito al feedback fornito in questo modulo. Non condivideremo le vostre informazioni per altri scopi. Tutte le informazioni di contatto fornite saranno conservate in conformità con la nostra Politica sulla privacy. Informativa sulla privacy.
Individuate un'opportunità di miglioramento?